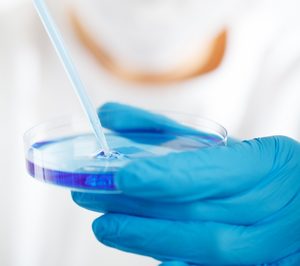
Secuvita aporta el 13,5% de los ingresos totales del grupo alemán VITA 34

El grupo alemán VITA 34, matriz de Secuvita y especialista en bancos privados de células madre de cordón umbilical incrementó su facturación un 22% en 2015, hasta los 18,5 M€, con un Ebitda de 3,9 M€ (+27,5%), y un resultado de 1,7 M€ (1 M en 2014). Secuvita, la filial española de VITA 34, representa el 13,5% de la facturación del grupo alemán, es decir, 2,49 M€ (2,83 M en 2014), con 14 trabajadores.
Entre los hitos más destacados de 2015, VITA 34 adquirió Vivocell Biosolutions, el mayor banco privado de células madre de Austria, y StemCare, banco de conservación de células madre de cordón umbilical que opera en Dinamarca, Suecia, Turquía y Rumanía. Firmó además un acuerdo de colaboración con Imunolita, el banco de células madre del Báltico, y continúa la colaboración con BioSave, su partner serbio.
Durante el primer trimestre de 2016, VITA 34 ha hecho nuevos socios en Dubai y el Líbano y actualmente tiene previsto expandir su negocio a Albania.